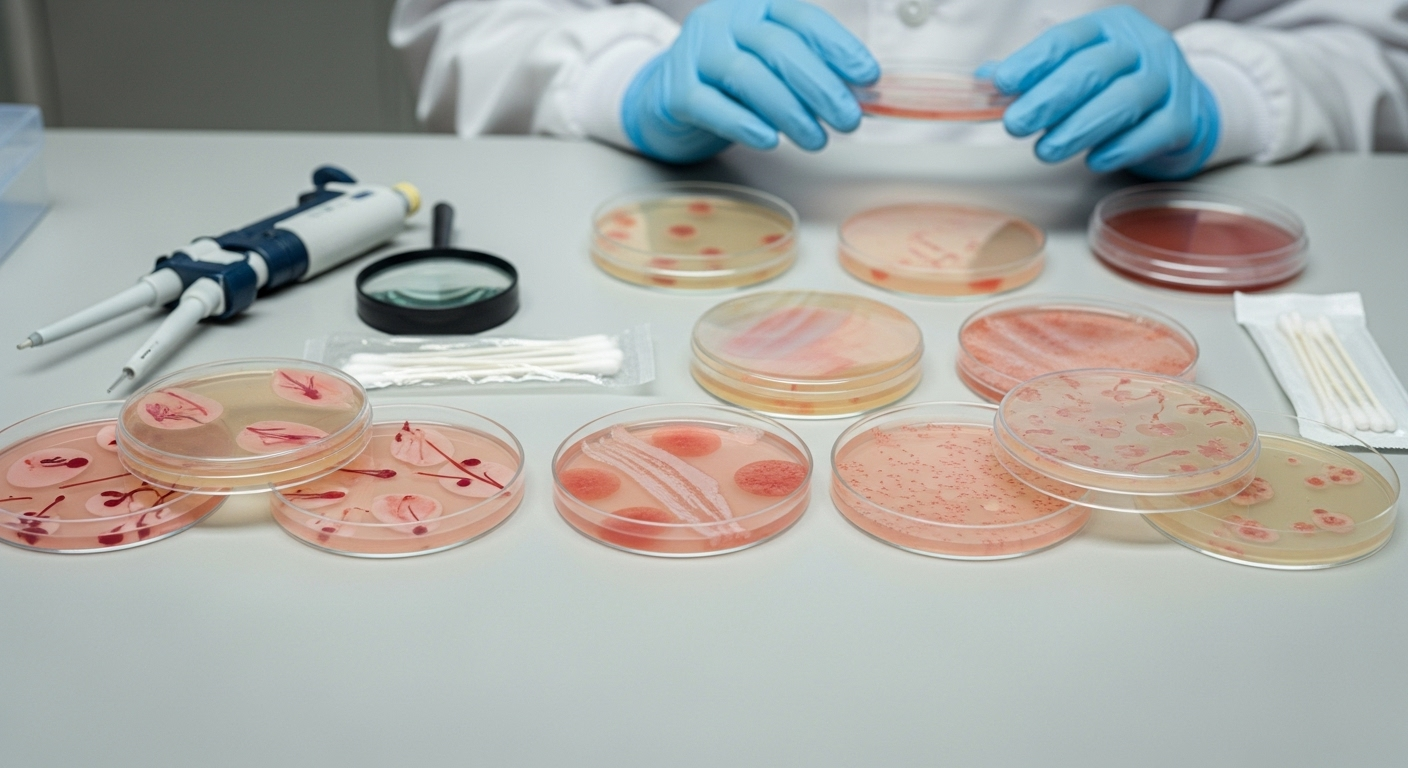
Et si le secret du rajeunissement se trouvait dans le sang de nos jeunes ?

L’idée de prendre le sang des jeunes pour redonner de la vigueur aux plus âgés… ça ressemble à un conte de fées, ou même à une histoire de vampires, n’est-ce pas ? On a tous entendu ces légendes. Et pourtant, figurez-vous que des scientifiques très sérieux se penchent sur la question depuis un moment. Une toute nouvelle étude vient de montrer comment, très concrètement, on pourrait peut-être redonner un vrai coup de jeune à notre peau grâce à cette méthode. C’est une piste fascinante, même si on en est qu’aux débuts.
Une expérience surprenante en laboratoire

Alors, comment ont-ils fait ? Des chercheurs, principalement d’une entreprise de soins de la peau en Allemagne, ont recréé une sorte de ‘peau humaine miniature’ en 3D dans leur laboratoire. C’est une technique de pointe. Ils ont ensuite testé l’effet du sérum de sang jeune sur ces cellules de peau. Et là, surprise : tout seul, le sérum ne faisait absolument rien. Aucun effet visible. On aurait pu croire que l’expérience était un échec.
Mais ils ne se sont pas arrêtés là. L’idée de génie a été d’ajouter un autre ingrédient à l’expérience : des cellules de moelle osseuse. Et c’est là que tout a changé. Dès que ces cellules ont été mises en contact avec le sérum de sang jeune, la peau miniature a commencé à recevoir des signaux de rajeunissement. C’est donc l’association des deux qui semble être la clé.
Comment mesure-t-on ce coup de jeune ?

C’est bien beau de parler de ‘rajeunissement’, mais comment est-ce qu’on le prouve ? Les scientifiques ont des outils très précis pour ça. Ils ont mesuré ce qu’on appelle ‘l’âge biologique’ de la peau en regardant des marqueurs dans son ADN. C’est un peu comme lire la date de naissance inscrite au plus profond de nos cellules. Et le résultat est sans appel : le sérum de sang jeune a bien réduit l’âge biologique de la peau.
Ce n’est pas tout. Ils ont aussi remarqué d’autres signes de jeunesse : les cellules de la peau montraient une activité métabolique bien plus élevée et elles se divisaient beaucoup plus vite, exactement comme le font les cellules jeunes. C’était une vraie cure de jouvence, mais à l’échelle microscopique.
Les protéines : les messagers secrets de la jeunesse

Mais alors, quel est le secret de cette interaction ? Qu’est-ce qui se passe exactement ? En analysant de plus près, les chercheurs ont découvert que la moelle osseuse, au contact du sang jeune, se mettait à produire 55 protéines différentes. Ces protéines agissent comme des petits messagers qui vont donner des ordres aux cellules de la peau.
Et parmi toutes ces protéines, ils en ont identifié sept qui sont déjà bien connues pour leur rôle crucial dans la jeunesse de la peau. On parle ici de protéines qui stimulent le renouvellement des cellules ou encore la fameuse production de collagène, cette substance qui donne à la peau sa fermeté et son élasticité. C’est comme si le sang jeune disait à la moelle osseuse de fabriquer la recette parfaite pour rajeunir la peau.
Attention, on n'y est pas encore !

Avant de s’emballer, il faut rester prudent. C’est une avancée formidable, vraiment, mais il est important de se rappeler que toute cette expérience a été menée en laboratoire, sur des cellules dans une boîte. C’est une chose de rajeunir un échantillon de peau, c’en est une autre de le faire sur une personne entière, avec toute la complexité du corps humain.
Les chercheurs sont les premiers à le dire : la prochaine étape, et c’est la plus importante, sera de vérifier si ces découvertes se confirment chez l’être humain. Il y a encore beaucoup de travail avant que cela ne débouche sur un traitement concret.
Pourquoi cette recherche est si importante pour nous tous

On pourrait se dire que tout ça, c’est juste pour effacer les rides. Mais ça va bien plus loin. Nous vivons de plus en plus vieux, et c’est une chance. Le défi, c’est de bien vieillir, de rester en forme et en bonne santé le plus longtemps possible. Notre corps n’est pas forcément ‘programmé’ pour rester en parfait état pendant 90 ans ou plus.
Ce genre de recherche ne vise pas seulement à nous faire paraître plus jeune. Le but est de comprendre les mécanismes du vieillissement pour pouvoir, un jour, prévenir les maladies qui y sont liées et nous aider à vivre nos dernières années avec plus de vitalité et moins de pépins de santé. C’est un espoir pour une vieillesse plus douce et plus active.
Conclusion : un espoir raisonnable pour l'avenir

En résumé, ce qui n’était qu’un mythe ancestral semble doucement trouver un écho dans la science moderne. Le sang jeune, lorsqu’il est associé aux cellules de la moelle osseuse, a bien le pouvoir d’envoyer des signaux de rajeunissement à notre peau. C’est prouvé, du moins en laboratoire. Le chemin est encore long, bien sûr, et il ne faut pas s’attendre à une fontaine de jouvence pour demain. Mais cette découverte ouvre une porte incroyablement prometteuse pour mieux comprendre et, peut-être un jour, mieux maîtriser le processus de vieillissement pour vivre mieux, plus longtemps.
Selon la source : sciencealert.com










